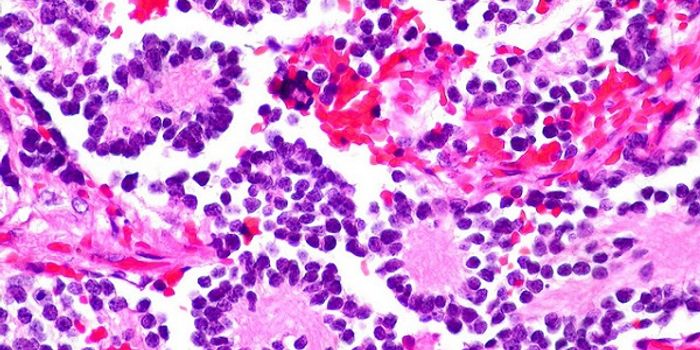
Shedding Light on Chemo

Plant disease response
The plant disease response is a multifaceted system based on the ability of the plant to recognize and identify foreign invading molecules. When a plant is exposed to a pathogen, the disease response system acts in a defensive manner, activating a variety of pathways. The plant can respond directly or indirectly to the pathogen.
-
JUN 08, 2016Genetics & GenomicsAs news of the Zika virus flooded the media for the past few months, efforts to control the mosquito population have sur ...Written By: Kara MarkerMAY 18, 2016ImmunologyYou probably won’t find a person who doesn’t agree that fruits and vegetables are “healthy.” Yet ...Written By: Kara MarkerMAY 16, 2016Health & MedicineThe first ever case of pulmonary veno-occlusive disease (PVOD) has been found for the first time ever in a dog. Doctors ...Written By: Kara MarkerAPR 29, 2016Cell & Molecular BiologyStarving immune cells of key nutrients thwarts their ability to launch an allergic response, according to new resea ...Written By: Futurity (futurity.org)MAR 30, 2016Health & MedicineMultiple Sclerosis (MS) is an autoimmune disease characterized by chronic inflammation, a result from an overexcited, mi ...Written By: Kara MarkerFEB 18, 2016MicrobiologyResearchers identified a new herpes virus that infects bats. Herpes viruses are double-stranded DNA viruses that infect ...Written By: Kerry EvansDEC 26, 2015ImmunologyPlants get infected with viruses just like what we do. Scientists recently discovered that a virus that infects the cowp ...Written By: Kara MarkerDEC 18, 2015Plants & AnimalsWhen it comes to insects and cold weather, many of them have a hard time surviving. This is because unlike humans, which ...Written By: Anthony BouchardNOV 15, 2015MicrobiologyIt’s now possible to sequence DNA from samples of irradiated bacteria, making it simpler and safer to identify pot ...Written By: Kerry EvansOCT 24, 2015Cell & Molecular BiologyThe mechanism by which the plant immune system operates is through the detection of conserved microbial components such ...Written By: Sarah HertrichOCT 05, 2015ImmunologyIn the past couple of years, increased appearance of the "gluten-free" label has been seen on products on groc ...Written By: Kara MarkerSEP 30, 2015Cell & Molecular BiologyPlant parasitic nematodes, such as the well-known root-knot nematode and the cyst nematode, invade plant roots near the ...Written By: Sarah HertrichSEP 15, 2015MicrobiologyResearchers at the University of Delaware have discovered a unique soil bacterium that boosts plant immunity in edible p ...Written By: Sarah HertrichSEP 09, 2015MicrobiologyBacillus thuringiensis is a Gram positive, soil-dwelling bacterium. Like all Bacillus species, it is rod-shaped an ...Written By: Kerry EvansAUG 27, 2015Plants & AnimalsIn Australia, wheat is identified as a significant economically important crop worth over $4.5 billion dollars per year. ...Written By: Sarah HertrichAUG 17, 2015MicrobiologyAgrobacterium tumefaciens is a plant pathogen responsible for crown gall disease. I know what you’re thinkin ...Written By: Kerry EvansAUG 14, 2015Plants & AnimalsThe CDC estimates the incidence of foodborne illness attributed to fruit and vegetable consumption at three million case ...Written By: Sarah HertrichAUG 02, 2015VideosThe USDA Agricultural Research Service (ARS) Bee Research Lab installed two beehives in 2010 and 2011 in order to help p ...Written By: Sarah HertrichJUL 15, 2015Health & MedicineKale, the current leafy green of choice for many health-savvy people in the United States, could potentially be under sc ...Written By: Kara MarkerJUL 09, 2015CancerPowerful diseases require powerful drugs or powerful doses of drugs, often with severe side effects. An optical control ...Written By: Ilene SchneiderJUL 07, 2015Plants & AnimalsDid you know that your precious pet could be harboring a bacteria that could potentially be harmful to you and your fami ...Written By: Sarah HertrichJUN 19, 2015Plants & AnimalsPlants and trees have often been used to treat diseases, in fact in ancient cultures, plants, roots, trees and other nat ...Written By: Brenda Kelley KimMAR 06, 2015Immunology
There are 4 known groups of HIV strains that affect humans. Two of them originated in western lowland gorillas in ...Written By: Robert WoodardMAR 05, 2015NeuroscienceSaying that sleep is an essential biological process is as obvious as saying that the sun rises every morning. Still, re ...Written By: Ilene Schneider
JUN 08, 2016
Genetics & Genomics
As news of the Zika virus flooded the media for the past few months, efforts to control the mosquito population have sur
...
Written By:
Kara Marker
MAY 18, 2016
Immunology
You probably won’t find a person who doesn’t agree that fruits and vegetables are “healthy.” Yet
...
Written By:
Kara Marker
MAY 16, 2016
Health & Medicine
The first ever case of pulmonary veno-occlusive disease (PVOD) has been found for the first time ever in a dog. Doctors
...
Written By:
Kara Marker
APR 29, 2016
Cell & Molecular Biology
Starving immune cells of key nutrients thwarts their ability to launch an allergic response, according to new resea
...
Written By:
Futurity (futurity.org)
MAR 30, 2016
Health & Medicine
Multiple Sclerosis (MS) is an autoimmune disease characterized by chronic inflammation, a result from an overexcited, mi
...
Written By:
Kara Marker
FEB 18, 2016
Microbiology
Researchers identified a new herpes virus that infects bats. Herpes viruses are double-stranded DNA viruses that infect
...
Written By:
Kerry Evans
DEC 26, 2015
Immunology
Plants get infected with viruses just like what we do. Scientists recently discovered that a virus that infects the cowp
...
Written By:
Kara Marker
DEC 18, 2015
Plants & Animals
When it comes to insects and cold weather, many of them have a hard time surviving. This is because unlike humans, which
...
Written By:
Anthony Bouchard
NOV 15, 2015
Microbiology
It’s now possible to sequence DNA from samples of irradiated bacteria, making it simpler and safer to identify pot
...
Written By:
Kerry Evans
OCT 24, 2015
Cell & Molecular Biology
The mechanism by which the plant immune system operates is through the detection of conserved microbial components such
...
Written By:
Sarah Hertrich
OCT 05, 2015
Immunology
In the past couple of years, increased appearance of the "gluten-free" label has been seen on products on groc
...
Written By:
Kara Marker
SEP 30, 2015
Cell & Molecular Biology
Plant parasitic nematodes, such as the well-known root-knot nematode and the cyst nematode, invade plant roots near the
...
Written By:
Sarah Hertrich
SEP 15, 2015
Microbiology
Researchers at the University of Delaware have discovered a unique soil bacterium that boosts plant immunity in edible p
...
Written By:
Sarah Hertrich
SEP 09, 2015
Microbiology
Bacillus thuringiensis is a Gram positive, soil-dwelling bacterium. Like all Bacillus species, it is rod-shaped an
...
Written By:
Kerry Evans
AUG 27, 2015
Plants & Animals
In Australia, wheat is identified as a significant economically important crop worth over $4.5 billion dollars per year.
...
Written By:
Sarah Hertrich
AUG 17, 2015
Microbiology
Agrobacterium tumefaciens is a plant pathogen responsible for crown gall disease. I know what you’re thinkin
...
Written By:
Kerry Evans
AUG 14, 2015
Plants & Animals
The CDC estimates the incidence of foodborne illness attributed to fruit and vegetable consumption at three million case
...
Written By:
Sarah Hertrich
AUG 02, 2015
Videos
The USDA Agricultural Research Service (ARS) Bee Research Lab installed two beehives in 2010 and 2011 in order to help p
...
Written By:
Sarah Hertrich
JUL 15, 2015
Health & Medicine
Kale, the current leafy green of choice for many health-savvy people in the United States, could potentially be under sc
...
Written By:
Kara Marker
JUL 09, 2015
Cancer
Powerful diseases require powerful drugs or powerful doses of drugs, often with severe side effects. An optical control
...
Written By:
Ilene Schneider
JUL 07, 2015
Plants & Animals
Did you know that your precious pet could be harboring a bacteria that could potentially be harmful to you and your fami
...
Written By:
Sarah Hertrich
JUN 19, 2015
Plants & Animals
Plants and trees have often been used to treat diseases, in fact in ancient cultures, plants, roots, trees and other nat
...
Written By:
Brenda Kelley Kim
MAR 06, 2015
Immunology
There are 4 known groups of HIV strains that affect humans. Two of them originated in western lowland gorillas in ...
Written By:
Robert Woodard
MAR 05, 2015
Neuroscience
Saying that sleep is an essential biological process is as obvious as saying that the sun rises every morning. Still, re
...
Written By:
Ilene Schneider